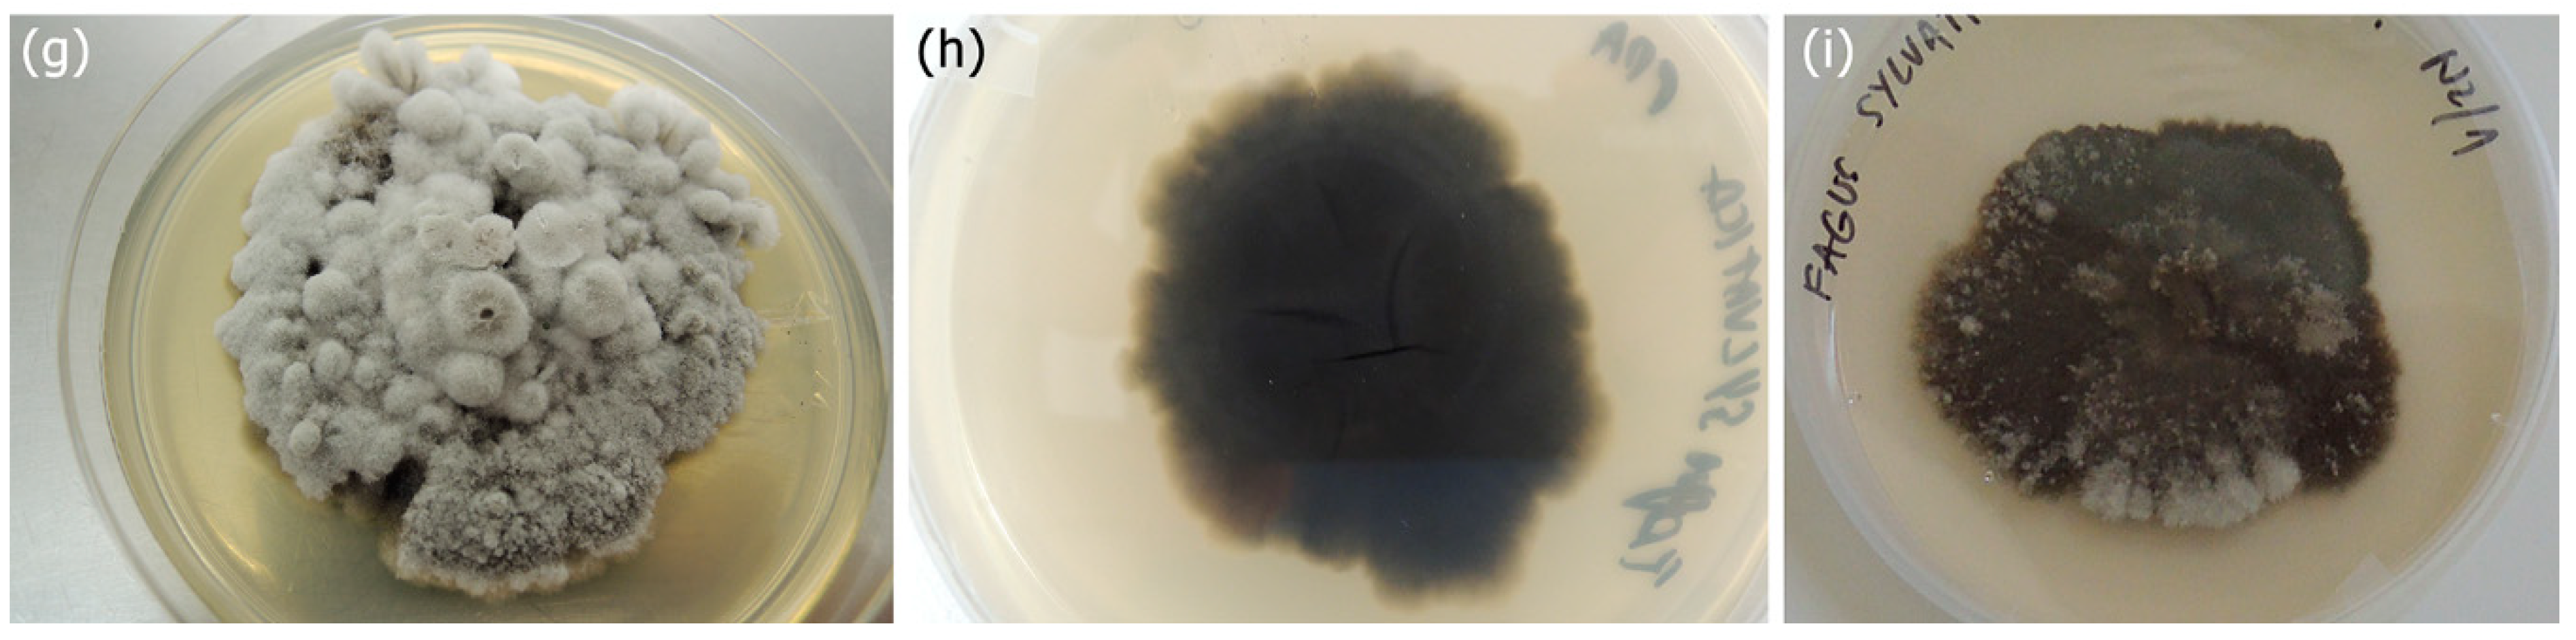
Forests 10 00718 g003b 550

1. Introduction
Pseudodidymella fagi C.Z. Wei, Y. Harada & Katum. is an ascomycete that was described in Japan in 1993, where it was associated with leaf blotch of Japanese beech,
Fagus crenata Blume [
1]. The sexual morph is formed over winter, and ascospores mature in late spring and initiate new infections of young beech leaves. Its pycnopleiospora asexual morph is formed under favourable conditions on necrotic leaf spots a few weeks after the initial infection has occurred. Conidia are responsible for secondary infections in summer [
1].
The first observation of the pathogen in Europe was in Switzerland in 2008, where it was identified on European beech (
Fagus sylvatica L.) as a new host [
2]. In 2016,
P. fagi was also identified in southern Germany on
F. sylvatica and on Oriental beech (
Fagus orientalis Lipsky) in the Munich Botanical Garden [
2] and in Austria [
3]. In 2017, the disease was recorded in Slovakia [
4]. Reports of
P. fagi spread in Europe indicate that it possesses the fundamental characteristics of an invasive alien species. However, this hypothesis still needs further testing [
2].
In 2018, leaf blotch of European beech was observed in central Slovenia. Leaves of F. sylvatica showed dark brown, irregularly shaped or confluent necrotic spots. Necrotic spots were more numerous on young plants and the lower branches of mature trees. The intensity of leaf blotch decreased progressively with increasing distance from the ground. To identify the causal agent, morphological and molecular analyses together with pathogenicity trials on F. sylvatica were used to identify and confirm the pathogen. In addition, pathogenicity tests were performed on other representative species of the Fagaceae family, i.e., F. orientalis, Castanea sativa Mill., and Quercus petraea (Matt.) Liebl., to test the possibility of a wider host range of P. fagi.
2. Materials and Methods
2.1. Sample Collection and Distribution of Pseudodidymella fagi
Leaves of F. sylvatica infected by P. fagi were found and collected in August 2018 in Kamniška Bela, in central Slovenia (46.32020° N, 14.60161° E, 620 m a.s.l.). The infected leaves were collected and deposited in the Mycotheca and Herbarium of the Slovenian Forestry Institute (LJF 7014–LJF 7016). In addition, further collection of European beech leaves from the leaf litter was done in spring 2019 to identify the sexual morph (LJF 7017).
Visually healthy leaves from representatives of the Fagaceae family were collected on 23 August 2018, for pathogenicity trials (
Table 1).
The Slovenia Forest Service (SFS) was used to report symptoms and send samples to confirm the pathogen and to determine its distribution in Slovenia.
2.2. Morphological Analyses
Symptomatic leaves were examined, photo-documented, and analyzed with an Olympus SZX16 stereomicroscope (Tokyo, Japan) with an Olympus UC90 camera (Münster, Germany), an Olympus BX53 microscope (Tokyo, Japan) with an Olympus DP26 camera (Tokyo, Japan), and an Olympus CellSens Standard v1.18 software.
Isolations from single or multiple conidium and/or ascospore were carried out by aseptically transferring single propagules from leaves to fresh malt-extract agar plates (MEA; 2% malt extract, 1.5% agar; Becton Dickinson, Sparks, MD, USA) and to potato dextrose agar plates (PDA; 3.9% potato dextrose agar; DifcoTM, Becton Dickinson, Sparks, MD, USA) with the tip of a scalpel and incubating them at 24 °C in the dark. In total, ten isolates from fruiting bodies were acquired. Representative isolates were deposited in the culture collection of the Laboratory of Forest Protection (Slovenian Forestry Institute, Ljubljana, Slovenia, ZLVG683 and ZLVG684).
For isolations from lesions on leaves, a procedure similar to that used by Gross, Beenken, Dubach, Queloz, Tanaka, Hashimoto and Holdenrieder [
2] was used—leaves were surface sterilized for 30 s in 80% ethanol, and squares of approximately 5 mm
2 of symptomatic tissue per leaf were excised and transferred to MEA plates amended with 100 mg L
−1 streptomycin (Sigma-Aldrich, St. Louis, MO, USA).
2.3. DNA Extraction, DNA Sequencing, and Identification
Genetic analyses were used to confirm the identity of the fungal propagules and obtained isolates. DNA was extracted from the mycelium, scraped from the MEA agar plates, or was extracted from 3–6 conidiomata carefully detached directly from infected leaves. Genomic DNA was extracted with a commercial NucleoSpin
® Plant II kit (Macherey Nagel, Düren, Germany) following the manufacturer’s protocol, after homogenizing the fungal material with a lysing matrix A tube (MP Biomedicals, Solon, OH, USA) using a Precellys Evolution device (Bertin Technologies, Montigny-le-Bretonneux, France). The internal transcribed spacer (ITS) region of the ribosomal DNA (rDNA) was amplified with primer pair ITS1 and ITS4 [
5]. The final volume of the amplification mixtures was 50 μL and contained 25 μL AmpliTaq Gold
® 360 Master Mix (Applied Biosystems, Foster City, CA, USA), 1 μL 360 GC Enhancer (Applied Biosystems), 3 μL each of 10 μM primers (Sigma-Aldrich), 4 μL of approximately 10 μg/mL extracted DNA, and 14 μL of nuclease-free water. The PCR conditions were as follows: 95 °C for an initial 10-min denaturation, 35 cycles of 94 °C for 1 min, annealing at 61.5 °C for 1 min and extension at 72 °C for 1 min, and a final extension at 72 °C for 10 min. The obtained PCR products were cleaned using a Wizard SV Gel and PCR Clean-Up System (Promega, Madison, WI, USA) and sequenced at a sequencing facility (Eurofins, Ebersberg, Germany) in both forward and reverse directions using the same primers as for the PCRs. Sequences were visualised and manually edited using Geneious Prime
® v.2019.0.3. (Biomatters Ltd., Auckland, New Zealand). Each sequence was used to perform individual nucleotide–nucleotide searches with the megablast algorithm from the NCBI website on 12 July 2019 [
6]. Representative sequences were deposited in the GenBank database.
2.4. Pathogenicity Tests
Pathogenicity tests were performed on representative tree species from the family Fagaceae:
Fagus sylvatica,
Fagus orientalis,
Castanea sativa, and
Quercus petraea. Visually healthy leaves of
F. sylvatica,
C. sativa, and
Q. petraea were collected in mixed broadleaved forests on 23 August 2018 (
Table 1). The leaves were rinsed with autoclaved distilled water and placed on moistened paper tissues in sterile glass plates (19 cm diameter, 4 cm height) as follows: four beech leaves per plate, four oak leaves per plate, and one sweet chestnut leaf per plate for a total of eight leaves per host. For inoculation, firstly three to six
P. fagi propagules on symptomatic
F. sylvatica leaves were morphologically and molecularly identified, and secondly the remaining propagules from infected
F. sylvatica leaves were carefully transferred with a sterile scalpel to the upper side of the leaves, which were included in the pathogenicity trials. Leaves of
F. sylvatica,
F. orientalis, and
Q. petraea were inoculated with five propagules and
C. sativa leaves with ten propagules. In total, there were 40 inoculation points for
F. sylvatica,
F. orientalis, and
Q. petraea, and 80 inoculation points for
C. sativa. Four non-inoculated healthy leaves of each species represented controls. After inoculation, leaves were incubated in petri dishes under daylight conditions at room temperature (22–25 °C). Paper tissues were periodically remoistened with sterile distilled water to avoid desiccation. The leaves were regularly inspected using an Olympus SZX16 stereomicroscope to monitor the infection process. After 22 days of incubation, re-isolations were carried out from the freshly developing conidiomata and from necrotic leaf tissues developing in the immediate vicinity of the inoculation points. Additional isolations from non-symptomatic leaves and controls were carried out to verify that no latent
P. fagi infections were present. For isolations from freshly developing conidiomata and for re-isolations from leaves, the same procedures were used as described in morphological analyses in
Section 2.2. The following number of samples were used for re-isolations per host: 36 samples for
F. sylvatica, 31 samples for
F. orientalis, 21 samples for
C. sativa, and 18 samples for
Q. petraea. Plates were incubated at 24 °C in the dark and regularly checked for mycelium growth for two weeks (negative controls for 29 days). Any outgrown mycelium was immediately transferred to fresh PDA and MEA plates. The isolates were grouped into morphotypes based on colony characteristics, and representative isolates from each morphotype were identified based on the ITS rDNA sequence.
4. Discussion
The disease symptoms caused by Pseudodidymella fagi on European beech were observed across a large part of Slovenia, which is now the fifth European country with a known presence of P. fagi. Susceptible hosts for P. fagi are known to be F. crenata, F. sylvatica, and F. orientalis, but the pathogenicity tests conducted in this study proved that P. fagi is also a potential pathogen for Q. petraea. Therefore, this study is the first confirmation of Koch’s postulates for P. fagi towards F. orientalis and Q. petraea.
It is still not clear whether
P. fagi is an overlooked pathogen that is causing more evident damage throughout Europe due to climatic changes or a newly introduced invasive species [
2]. It is probable that the similar symptomatology compared to
Apiognomonia errabunda (Roberge ex Desm.) Höhn. concealed the earlier discovery of
P. fagi in Slovenia. Numerous recent reports of
P. fagi occurring in Europe support the hypothesis that
P. fagi was introduced into Europe, most likely from Asia [
1,
7], but further genetic studies are needed to appropriately address this question.
Visually healthy leaves of the four tree species were inoculated with propagules of
P. fagi. Even though 19–74% of the inoculation spots developed lesions under or in the immediate vicinity of the propagule, re-isolations from those regions did not always yield the culture of
P. fagi. Furthermore, re-isolation of
P. fagi after artificial infection proved to be difficult and resulted in a very low success rate for all tested species. On the other hand, numerous other fungi were re-isolated from the necrotic leaf spots under the inoculation points, such as
Colletotrichum sp. from European beech and Oriental beech,
Paraphaeosphaeria sp. from sessile oak, and
Gnomoniopsis smithogilvyi from sweet chestnut. Some of the identified species are well-known endophytes [
8,
9,
10,
11]. We speculate that endophytes could have an important role in competing with
P. fagi for the same substrate or could have a role in the development of necrosis. Additionally, endophytes could play a decisive role in combating the future spread of
P. fagi across Europe, as is also known for other endophytic fungi [
12,
13]. As such, the role of endophytes in the development and spread of the disease caused by
P. fagi should be investigated in the future.
Our study reports the first finding of
P. fagi in Slovenia and its further spread in Europe towards the south. We confirmed the pathogenicity of
P. fagi towards
F. sylvatica. This is the first study that confirmed
F. orientalis as a host, in agreement with Koch’s postulates. Our in vitro inoculation experiment showed potential pathogenicity towards
Q. patraea and
C. sativa, which is the first report of new potential hosts for
P. fagi in Europe. However, no characteristic symptoms for
P. fagi were observed in the field on
Q. petraea and
C. sativa leaves. Re-isolations of the pathogen from inoculated
C. sativa leaves were not successful. However,
C. sativa seems to be partially susceptible in vitro because 19% of inoculation points developed lesions. Koch’s postulates could not be fulfilled for
C. sativa; nevertheless, it is possible that the observed necroses were caused by
P. fagi and its re-isolation failed because re-isolations of
P. fagi proved to be difficult for all tested species. In the field, numerous heavily damaged leaves of common hornbeam (
Carpinus betulus L.) were observed in the immediate vicinity of European beech heavily infected by
P. fagi. Macroscopic examination showed that some necrotic lesions on
C. betulus leaves developed underneath or in the immediate vicinity of the mycopappus-like propagules of
P. fagi. However, no newly developed propagules were found on those lesions. We hypothesize that
C. betulus could be another possible host, where
P. fagi acts as a weak pathogen. Therefore, extended pathogenicity tests should be performed that would include representatives from the Fagales order, i.e., from the following genera:
Alnus,
Betula,
Carpinus,
Corylus, and
Ostrya. We are most likely witnessing host jumps and host switching of
P. fagi [
2,
7,
14], and close monitoring of this arising pathogen throughout Europe would clarify the situation of the disease on other hosts.